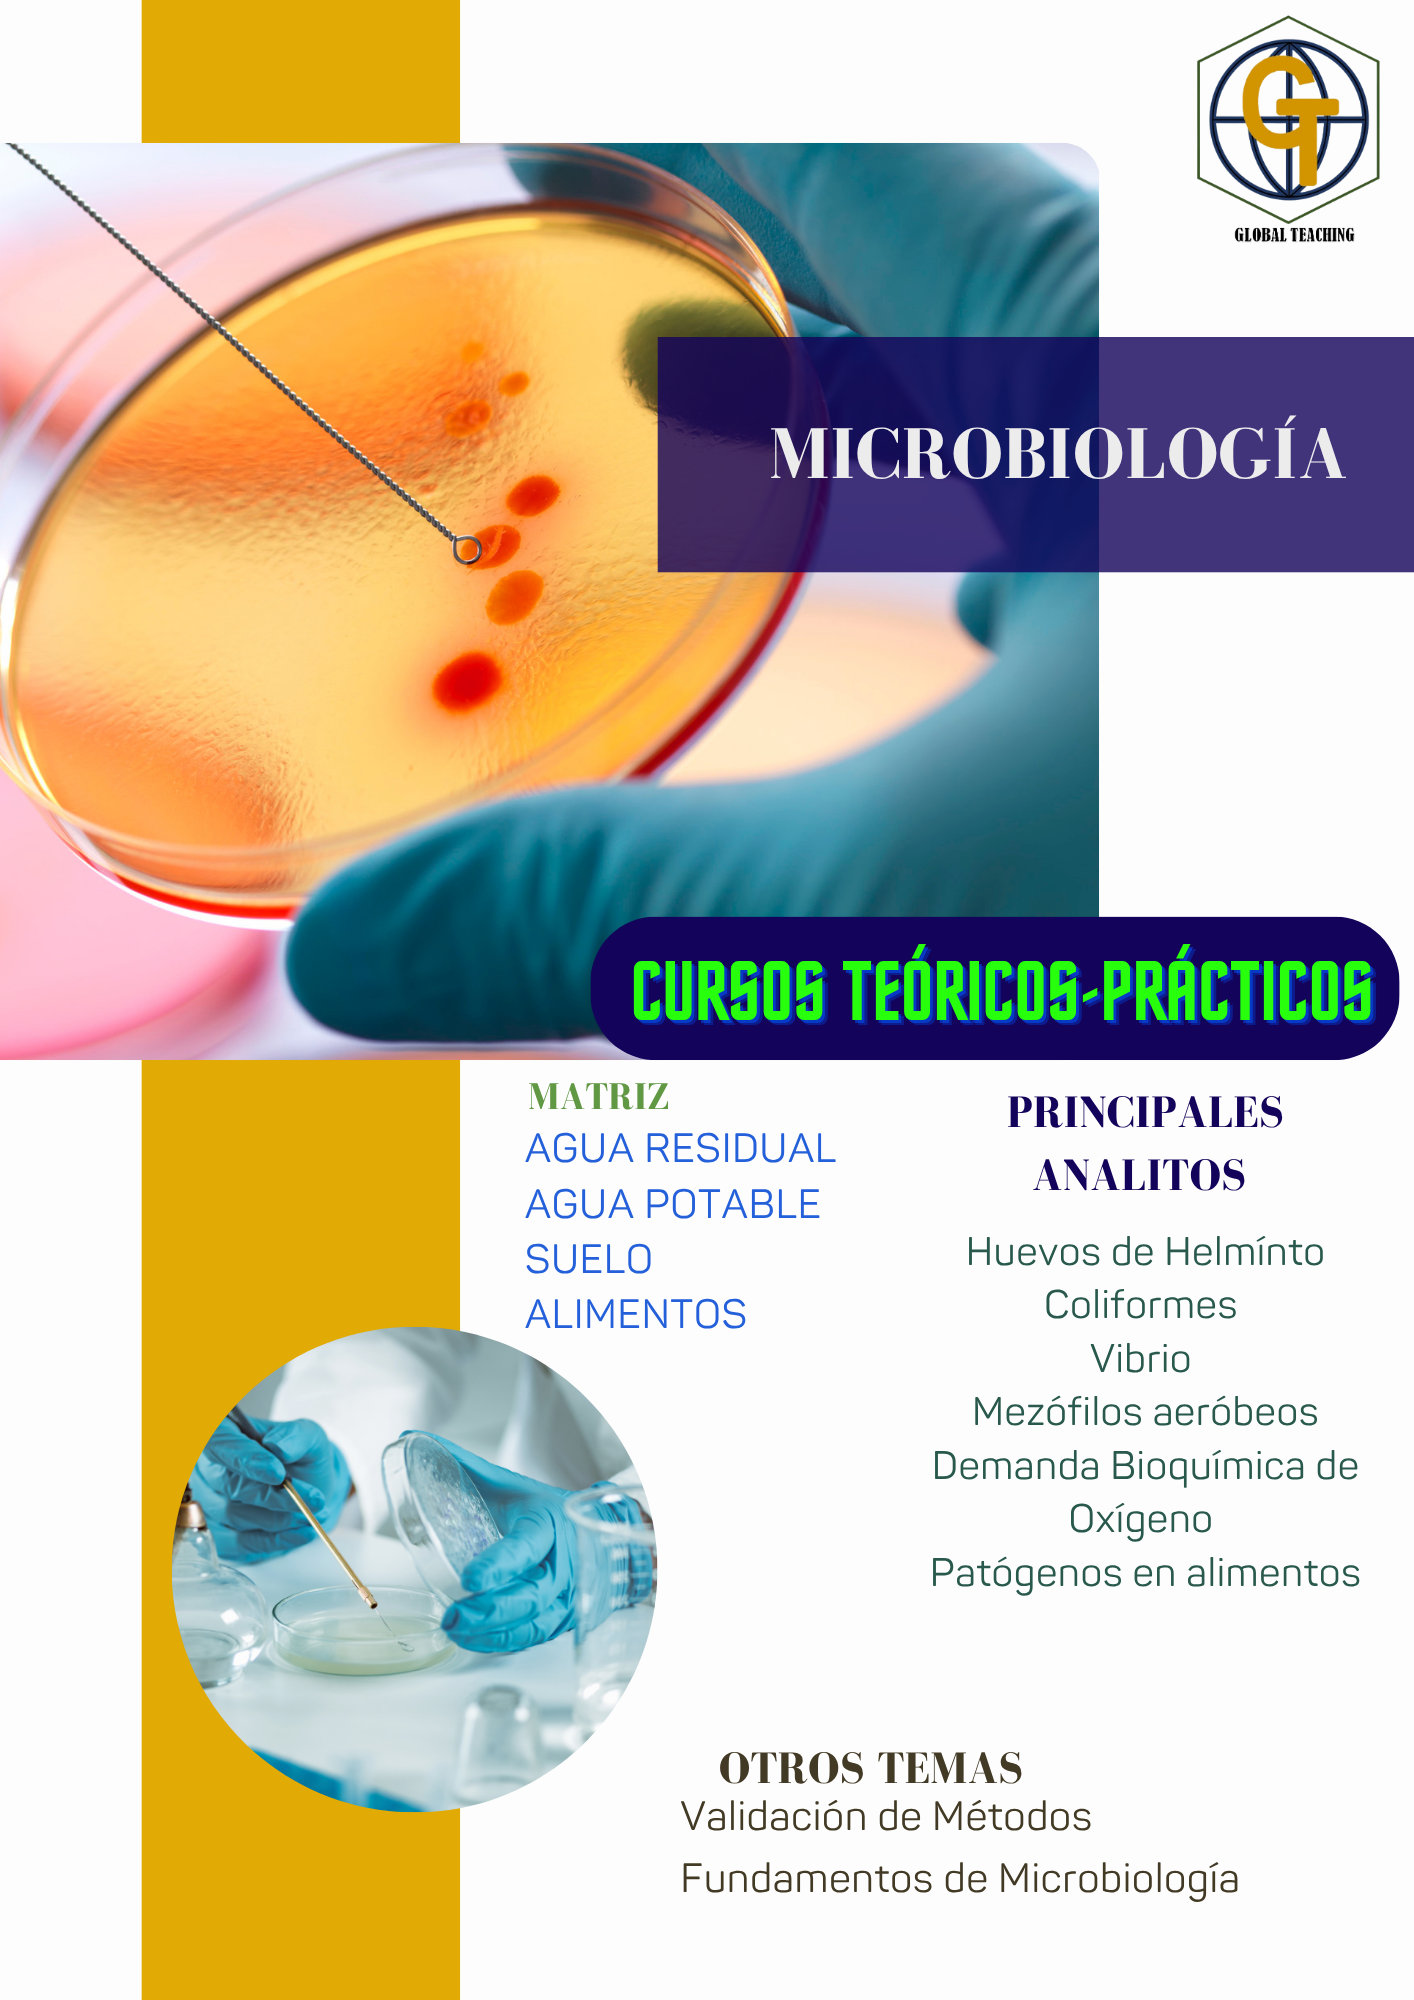
Servicios para Laboratorios de Ensayo

Descubre nuestras soluciones especializadas para Laboratorios de Ensayo, diseñadas para optimizar procesos, garantizar la calidad y cumplir con normativas clave 📊🔬 🧪 Implementación de ISO 17025: Fortalecemos la competencia técnica y la confiabilidad en resultados de ensayo. ⚙️ Validación de Métodos Analíticos: Desarrollo y verificación de procedimientos para garantizar precisión y exactitud. 📑 Gestión de la Calidad en Laboratorios: Estrategias para mejorar eficiencia operativa y cumplimiento regulatorio. 🔍 Espectrofotometría y Análisis Instrumental: Optimización de técnicas analíticas para asegurar mediciones confiables. 📈 Desarrollo de Procedimientos Normalizados: Creación de documentos y protocolos alineados con estándares internacionales.